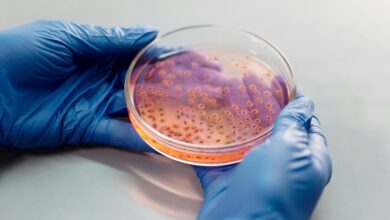

Ανατρεπτική μελέτη: Η γήρανση δεν είναι αργή – Οι δυο καθοριστικές ηλικιακές «κορυφές»

Η γήρανση μοιάζει, για τους περισσότερους, με μια αργή και σταδιακή διαδικασία. Νέα επιστημονικά δεδομένα όμως έρχονται να αμφισβητήσουν αυτή την εικόνα, δείχνοντας ότι το ανθρώπινο σώμα δεν «παλιώνει» ομαλά, αλλά περνά από δύο έντονες φάσεις επιτάχυνσης.
Σύμφωνα με μελέτη που δημοσιεύτηκε το 2024 στο επιστημονικό περιοδικό Nature Aging, οι πιο απότομες βιολογικές αλλαγές παρατηρούνται κατά μέσο όρο γύρω στα 44 και ξανά στις αρχές της δεκαετίας των 60.
«Δεν αλλάζουμε απλώς σταδιακά με τον χρόνο· υπάρχουν στιγμές πραγματικά δραματικών μεταβολών», εξηγεί ο γενετιστής Michael Snyder από το Stanford University, ένας από τους επικεφαλής της έρευνας. «Τα μέσα της δεκαετίας των 40 και οι αρχές των 60 αποτελούν κρίσιμα σημεία, ανεξάρτητα από το ποια κατηγορία μορίων εξετάζουμε».
Η ερευνητική ομάδα παρακολούθησε 108 ενήλικες ηλικίας 25 έως 70 ετών, οι οποίοι παρείχαν βιολογικά δείγματα κάθε λίγους μήνες επί σειρά ετών. Συνολικά, οι επιστήμονες ανέλυσαν περισσότερα από 135.000 βιολογικά χαρακτηριστικά: RNA, πρωτεΐνες, λιπίδια, καθώς και μικροβιακούς πληθυσμούς από το έντερο, το δέρμα, τη μύτη και τη στοματική κοιλότητα.
Ο όγκος των δεδομένων ήταν τεράστιος: κατά μέσο όρο, κάθε συμμετέχων έδωσε 47 δείγματα μέσα σε 626 ημέρες, ενώ ένας εθελοντής έφτασε τα 367 δείγματα. Αυτό μεταφράστηκε σε περισσότερα από 246 δισεκατομμύρια δεδομένα, τα οποία αναλύθηκαν αναζητώντας μοτίβα που σχετίζονται με τη γήρανση.
Τα αποτελέσματα ήταν εντυπωσιακά. Περίπου το 81% των μορίων που μελετήθηκαν παρουσίασε σημαντικές μεταβολές σε μία ή και στις δύο «πικ» ηλικίας. Η πρώτη εμφανίζεται στα μέσα της δεκαετίας των 40, ενώ η δεύτερη στις αρχές των 60, με διαφορετικό όμως βιολογικό «αποτύπωμα» κάθε φορά.
- τον μεταβολισμό των λιπιδίων,
- τον τρόπο που ο οργανισμός επεξεργάζεται την καφεΐνη και το αλκοόλ,
- δείκτες καρδιαγγειακής υγείας,
- τη λειτουργία του δέρματος και των μυών.
- τον μεταβολισμό των υδατανθράκων και της καφεΐνης,
- την καρδιαγγειακή λειτουργία,
- τη ρύθμιση του ανοσοποιητικού,
- τη νεφρική λειτουργία καθώς και εκ νέου με δέρμα και μυϊκό σύστημα.
Οι επιστήμονες παρατήρησαν ότι ο κίνδυνος για ορισμένες παθήσεις –όπως καρδιαγγειακά νοσήματα ή νευροεκφυλιστικές ασθένειες– δεν αυξάνεται γραμμικά με την ηλικία, αλλά εκτοξεύεται μετά από συγκεκριμένα ηλικιακά όρια. Αυτό ακριβώς προσπάθησαν να ερμηνεύσουν μέσα από τους βιολογικούς δείκτες.
Ένα εύλογο ερώτημα αφορά τον ρόλο της εμμηνόπαυσης, καθώς συμπίπτει χρονικά με την πρώτη «κορυφή». Οι ερευνητές όμως ξεκαθαρίζουν ότι δεν πρόκειται για καθοριστικό παράγοντα. Παρόμοιες μοριακές αλλαγές παρατηρήθηκαν και στους άνδρες της ίδιας ηλικίας.
Όπως εξηγεί ο πρώτος συγγραφέας της μελέτης, ο επιστήμονας Xiaotao Shen, «η εμμηνόπαυση μπορεί να συμβάλλει στις αλλαγές που βλέπουμε στις γυναίκες, όμως υπάρχουν σαφώς πιο γενικοί και σημαντικοί μηχανισμοί που επηρεάζουν και τα δύο φύλα». Η αναζήτηση αυτών των μηχανισμών, τονίζει, πρέπει να αποτελέσει προτεραιότητα για την επόμενη φάση της έρευνας.
Τι σημαίνουν όλα αυτά; Η μελέτη ενισχύει την ιδέα ότι η γήρανση δεν είναι μια ευθεία γραμμή, αλλά μια διαδικασία με «σκαλοπάτια». Παρόμοια ευρήματα έχουν καταγραφεί και σε πειραματόζωα – από μύγες και ποντίκια έως ψάρια – γεγονός που υποδηλώνει ότι η σταδιακή αλλά και βήμα-βήμα γήρανση μπορεί να είναι θεμελιώδες βιολογικό χαρακτηριστικό.
Οι ίδιοι οι ερευνητές πάντως επισημαίνουν ότι το δείγμα είναι σχετικά μικρό και περιορίζεται σε συγκεκριμένες ηλικίες και τύπους βιολογικών δειγμάτων. Μελλοντικές μελέτες, με περισσότερους συμμετέχοντες και μεγαλύτερο ηλικιακό εύρος, θα μπορούσαν να φωτίσουν ακόμη περισσότερο το φαινόμενο.
Ωστόσο, το μήνυμα είναι ήδη σαφές: αν κάποιος γύρω στα 44 ή λίγο μετά τα 60 νιώσει ότι «γέρασε απότομα», η αίσθηση αυτή ίσως να έχει πραγματική βιολογική βάση. Και η κατανόηση αυτών των κρίσιμων φάσεων μπορεί στο μέλλον να οδηγήσει σε πιο στοχευμένες παρεμβάσεις, ώστε η γήρανση να γίνει όχι απαραίτητα πιο αργή, αλλά πιο υγιής.